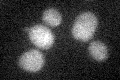
YBR008C
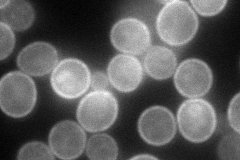
YBR008C
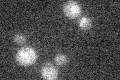
YBR008C

View description
Plasma membrane multidrug transporter of the major facilitator superfamily, involved in efflux of fluconazole, diazaborine, benomyl, methotrexate, and other drugs; expression induced in cells treated with the mycotoxin patulin
Localization:
Intensity:
Fold change:
Significance:
-
C’ GFP library in SD
below threshold16.26 -
N' NOP1pr-GFP in SD
cell periphery99.2392 -
N' TEF2pr-mCherry in SD

cell periphery,vacuole178.475 -
N' NATIVEpr-GFP in SD

below threshold16.2185 -
N' TEF2pr-VC and Cyto-VN in SD

cell periphery,punctate30.3718 -
C’ GFP library in SD+DTT

cytosol15.340.94No -
C’ GFP library in SD+H2O2

cytosol23.251.42No -
C’ GFP library in Starvation Media
cytosol18.251.12No -
C’ GFP library on the background of Pup2-DaMP

below threshold -
C’ GFP library on the background of CCT mutant

below threshold14.60740.897996No
